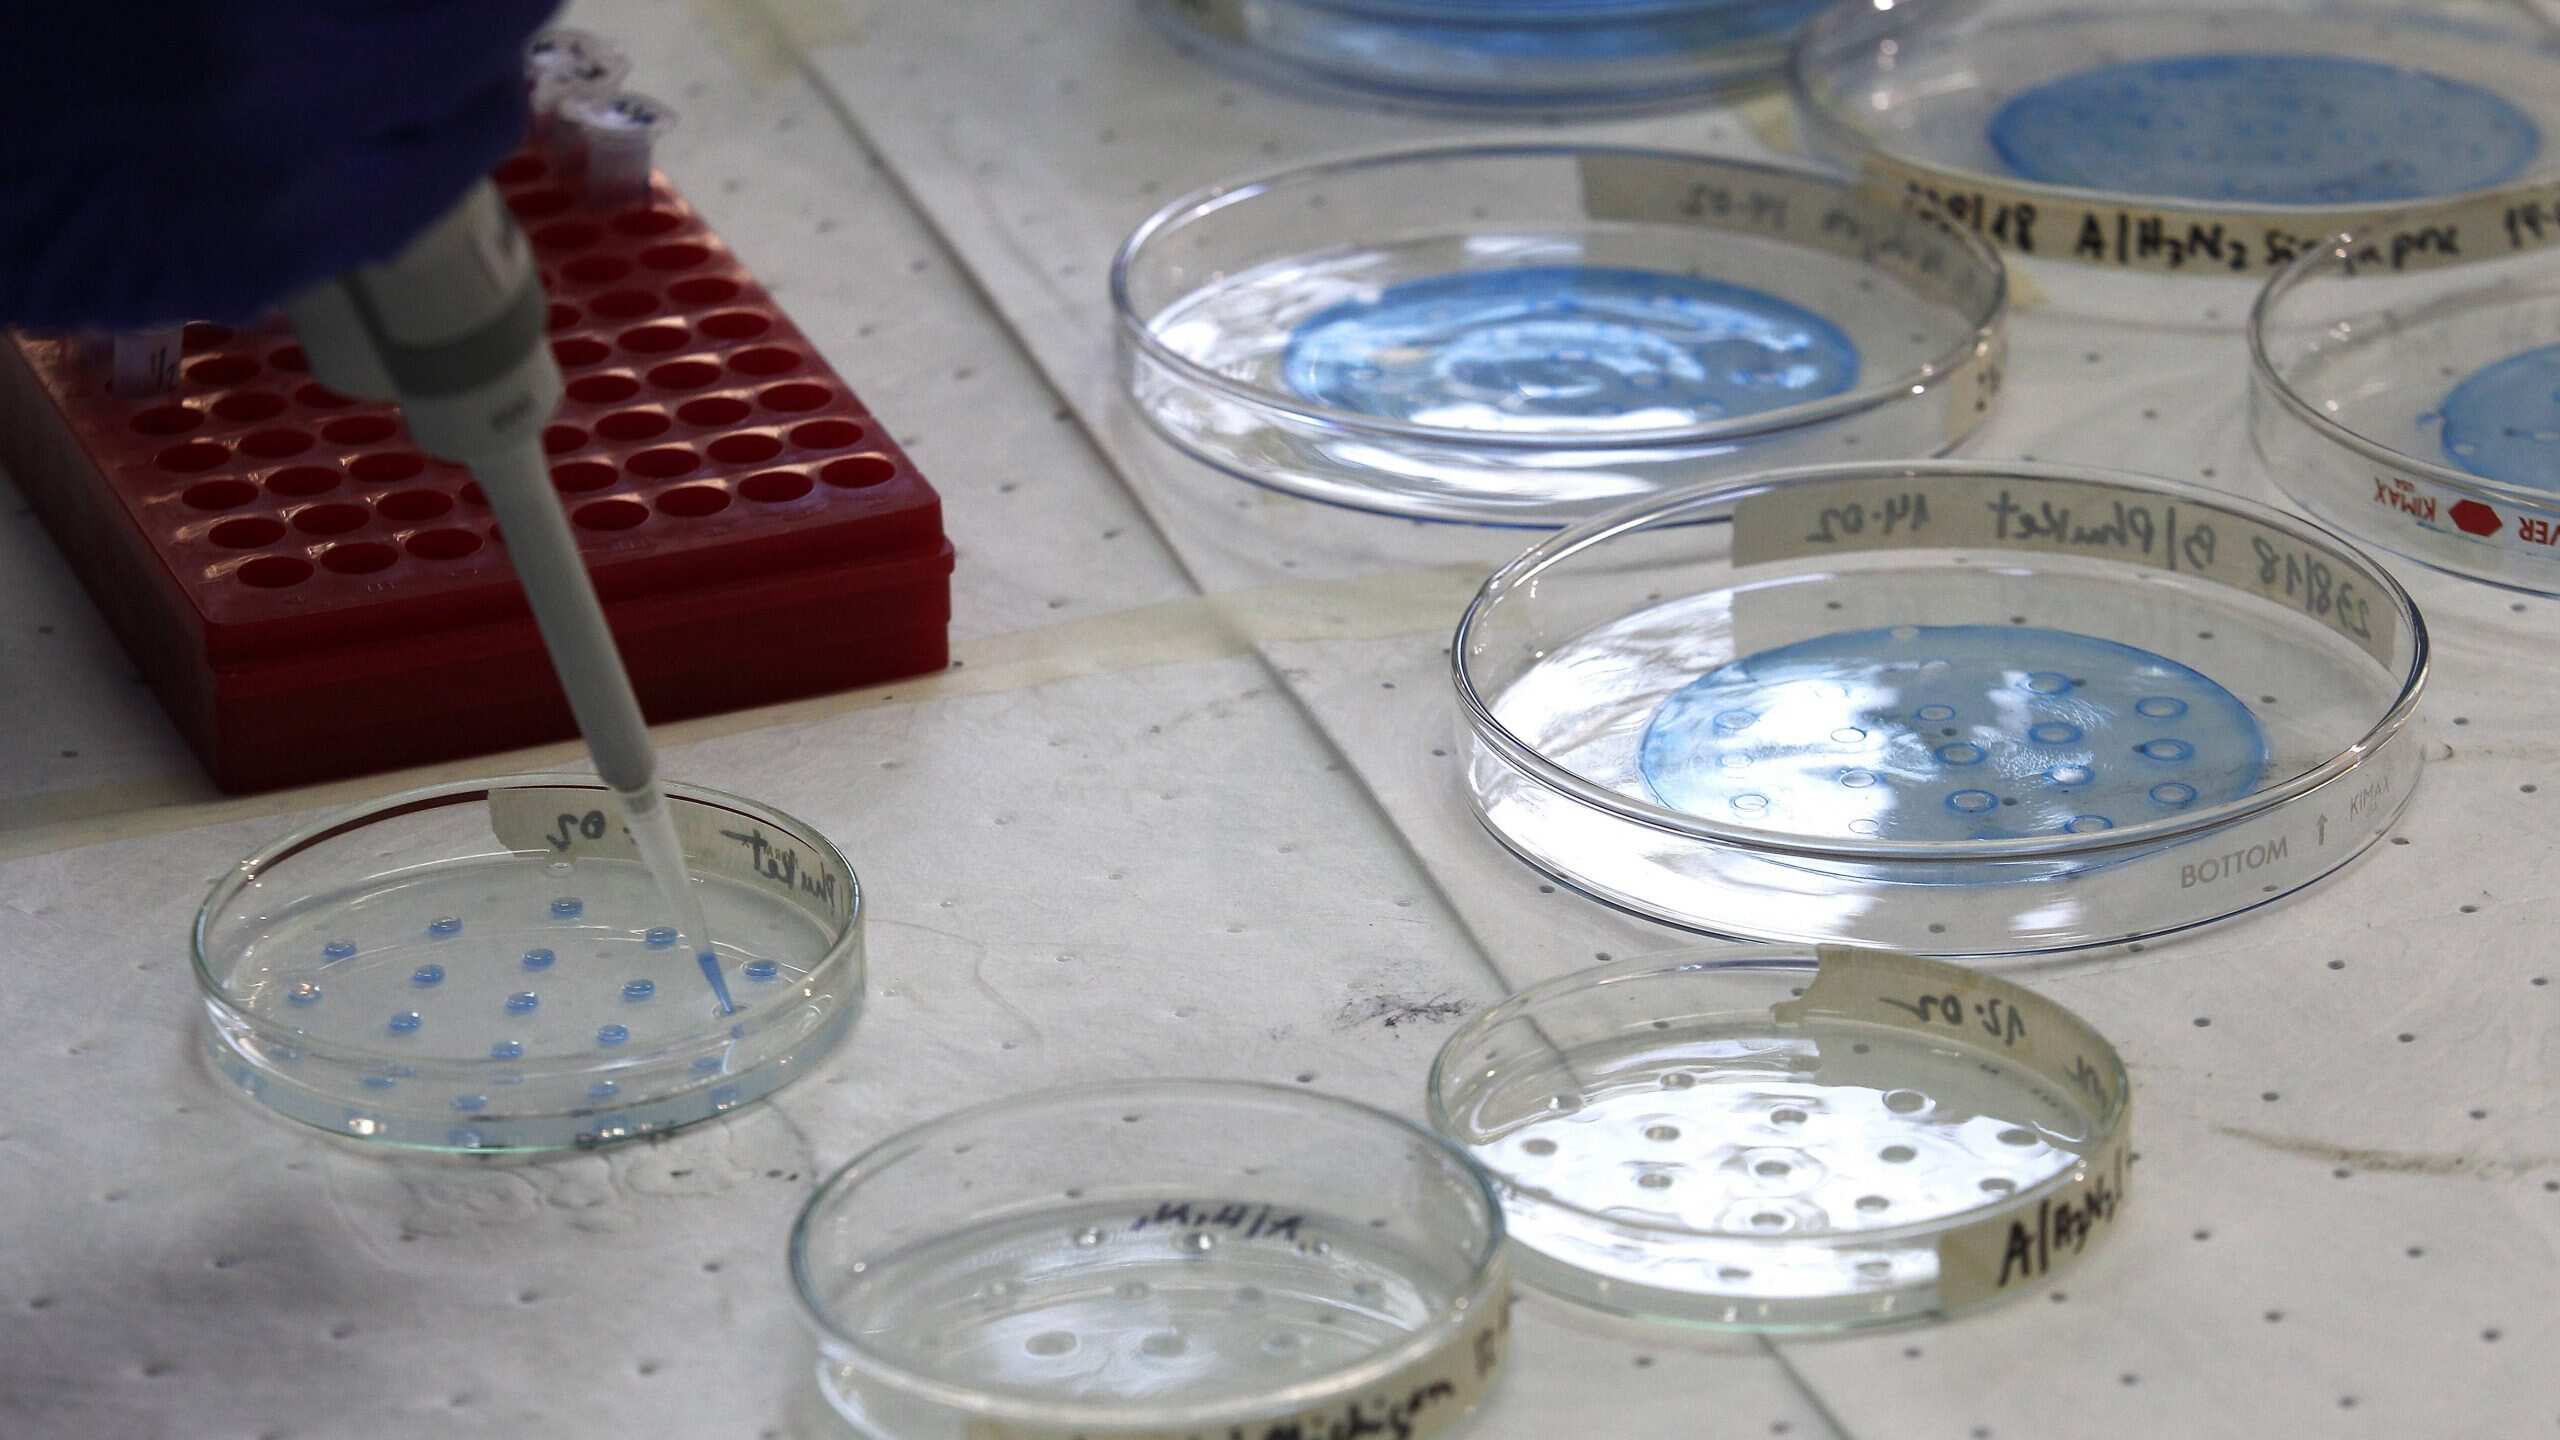

El Ministerio de Salud dio a conocer este martes un nuevo reporte sobre los casos de coronavirus en Chile.
Al respecto, el subsecretario de Redes Asistenciales Arturo Zúñiga indicó que en las últimas 24 horas se registraron 289 casos nuevos, acumulando un total de 2.738 desde el 3 de marzo.
Además, confirmó cuatro nuevos fallecidos por covid-19, lo que da un total de 12 víctimas fatales desde el inicio de la emergencia.
La autoridad indicó que los nuevos decesos corresponden a personas adultas con otras enfermedades de base. En ese sentido, precisó que un caso es de la Región de Valparaíso, uno de la Metropolitana y dos en La Araucanía.